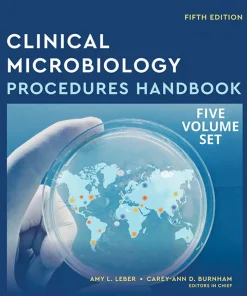
ASM Press Clinical Microbiology Procedures Handbook Multi-Volume

Shop
Showing 4258–4266 of 26071 results
-
Sale!

Asim and Shoaib Gynaecology & Obstetrics Fcps 1 2nd Edition
Original price was: د.إ200.00.د.إ150.00Current price is: د.إ150.00. Add to cart Quick View Compare -

Asim and Shoaib Gynaecology & Obstetrics Fcps 1 2nd Edition
Call for Price Price Ask Via WhatsApp Quick View Compare -
Sale!

Asim and Shoaib Medicine and Allied FCPS 1 5th Edition
Original price was: د.إ200.00.د.إ120.00Current price is: د.إ120.00. Add to cart Quick View Compare -
Sale!

Asim and Shoaib Surgery and Allied FCPS 1 5th Edition
Original price was: د.إ400.00.د.إ250.00Current price is: د.إ250.00. Add to cart Quick View Compare -
Sale!

ASMAS RADIOLOGY GUIDE A Comprehensive Guide to IMM MCPS AND FCPS II Exams
Original price was: د.إ250.00.د.إ180.00Current price is: د.إ180.00. Add to cart Quick View Compare